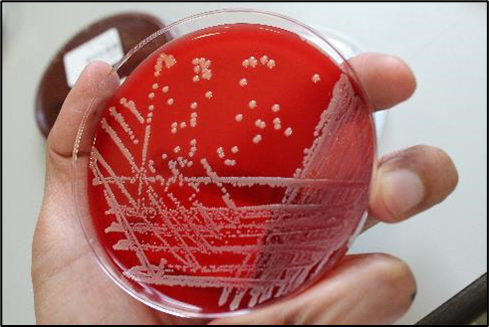

Continuing the Girlymicro theme of raising awareness of roles outside the laboratory to Celebrate National Pathology Week 2022 today we have the inspiring Anthony De Souza sharing his journey from bench scientist to Practice Educator. I’ve already written about why I think it’s so important that Healthcare Scientists think of themselves as educators (see blog here) but Ant puts this into practice and talks about how he became a Practice Educator and why these roles are so important.

I was a geeky kid and was pretty obsessed with astronomy, pathology and nature. I was an avid reader and loved to immerse myself in my mother’s nursing textbooks! I mean, I used to peruse the BNF for fun and at church book sales I wanted medical textbooks.
In my teens I pondered whether to become a marine biologist, a science teacher, a dietician or scientist. After looking through four heaving A4 binders of job descriptions in our school careers corner I settled on Biomedical Scientist, more specifically in Microbiology.
It was a career that allowed me to immerse myself in the medical world without being too close to the patient, something which I thought I may struggle with. My first taste of Microbiology at A-Level was a lesson on bacterial culture which involved bacterial streaking. From this point microbiology sparked an interest that I knew would always be there. After completing my IBMS accredited degree I was very lucky to get a trainee band 5 position in my local micro lab closer to home!
As time went on, I developed within Microbiology spanning a ten-year period. I realised that some of the most enjoyable parts of my role were when I taught or trained others, especially if they shared the same excitement I did. In every job I had I always ended up being known as a good teacher, and knew I wanted to get more involved, but being a teacher full time didn’t appeal to me.
As an experienced band six I started to feel frustrated, felt like I had peaked within my current role and needed something to fundamentally change. It was at this point that I seriously considered leaving the NHS and using my transferable skills in a different place. I’ve always felt confident in my abilities to work in different settings and environments with different people, I just needed the opportunity. That’s when I was encouraged to apply for a job as a part time practice educator in our hospital. Up until this point, I had only ever heard of this role in a nursing context.
‘Most things feel impossible till it’s done’ – Nelson Mandela
During the application for this part time role, I had full on imposter syndrome and was talking myself out of applying. One of the biggest self-imposed barriers was feeling like I was leaving behind certainty and proven experience for a role in which I would need to build and grow within. I had gotten to the point where work felt comfortable, my knowledge and skills were developed for my role, and I felt confident in that. The thought of moving to an area outside of my core experience base was pretty terrifying but I knew I had to do it! I decided to apply and was successful in the interview!
Some of the key purposes of the role are outlined below:
- Work to support learning and education and support specific workstreams, in my case this was Healthcare Science.
- Create and maintain positive learning environments
- Facilitating induction, education and continuing professional development
- Encourage practice development, support service improvement
- Promote high standards of care and act as a role model for others
- Work multi-professionally, as needed
After being used to working in a small team within the lab my new role involved an even bigger and more diverse team. This exposed me to a greater appreciation for the work of other health professionals and the hospital as a whole.
At first, I found the job challenging; learning new names, getting to know the team, my place within it, learning new acronyms during meetings and adjusting to the different styles of communication. Some of my work involved supporting healthcare science learners, acting as a point of contact to raise issues, signposting relevant training & education and supporting outreach and engagement activities. As my role grew and developed, I was able to work more multi-professionally, increasing the visibility of our hidden workforce and even teaching nurses about healthcare science.
As a practice educator a PG Cert in Practice Education is essential to learn about educational theories and how this relates to designing learning for the learner. Whilst I may have been acting on natural instinct before gaining this qualification, the education and evidence-based practice approach to back up teaching has been important in the role.
This role could suit a range of individuals but ultimately this would suit someone who wants to make a difference, is passionate about education and training, has the ability to communicate well, work effectively with others and enjoys working both alone and with different teams. The job often involves taking yourself out of your comfort zone and identifying opportunities to share and develop learning.
Whilst I have now left the lab and am working full time as a practice educator, I still do look back fondly on my lab days and Microbiology. I love checking in on the lab and looking at exciting agar plates and learning about exciting cases, and who knows maybe one day I’ll go back for now though I am fully committed to this new direction. Just because I’ve left the lab, doesn’t mean its left me….
Follow Ant on Twitter @ADSMicro to find out more
All opinions on this blog are my own